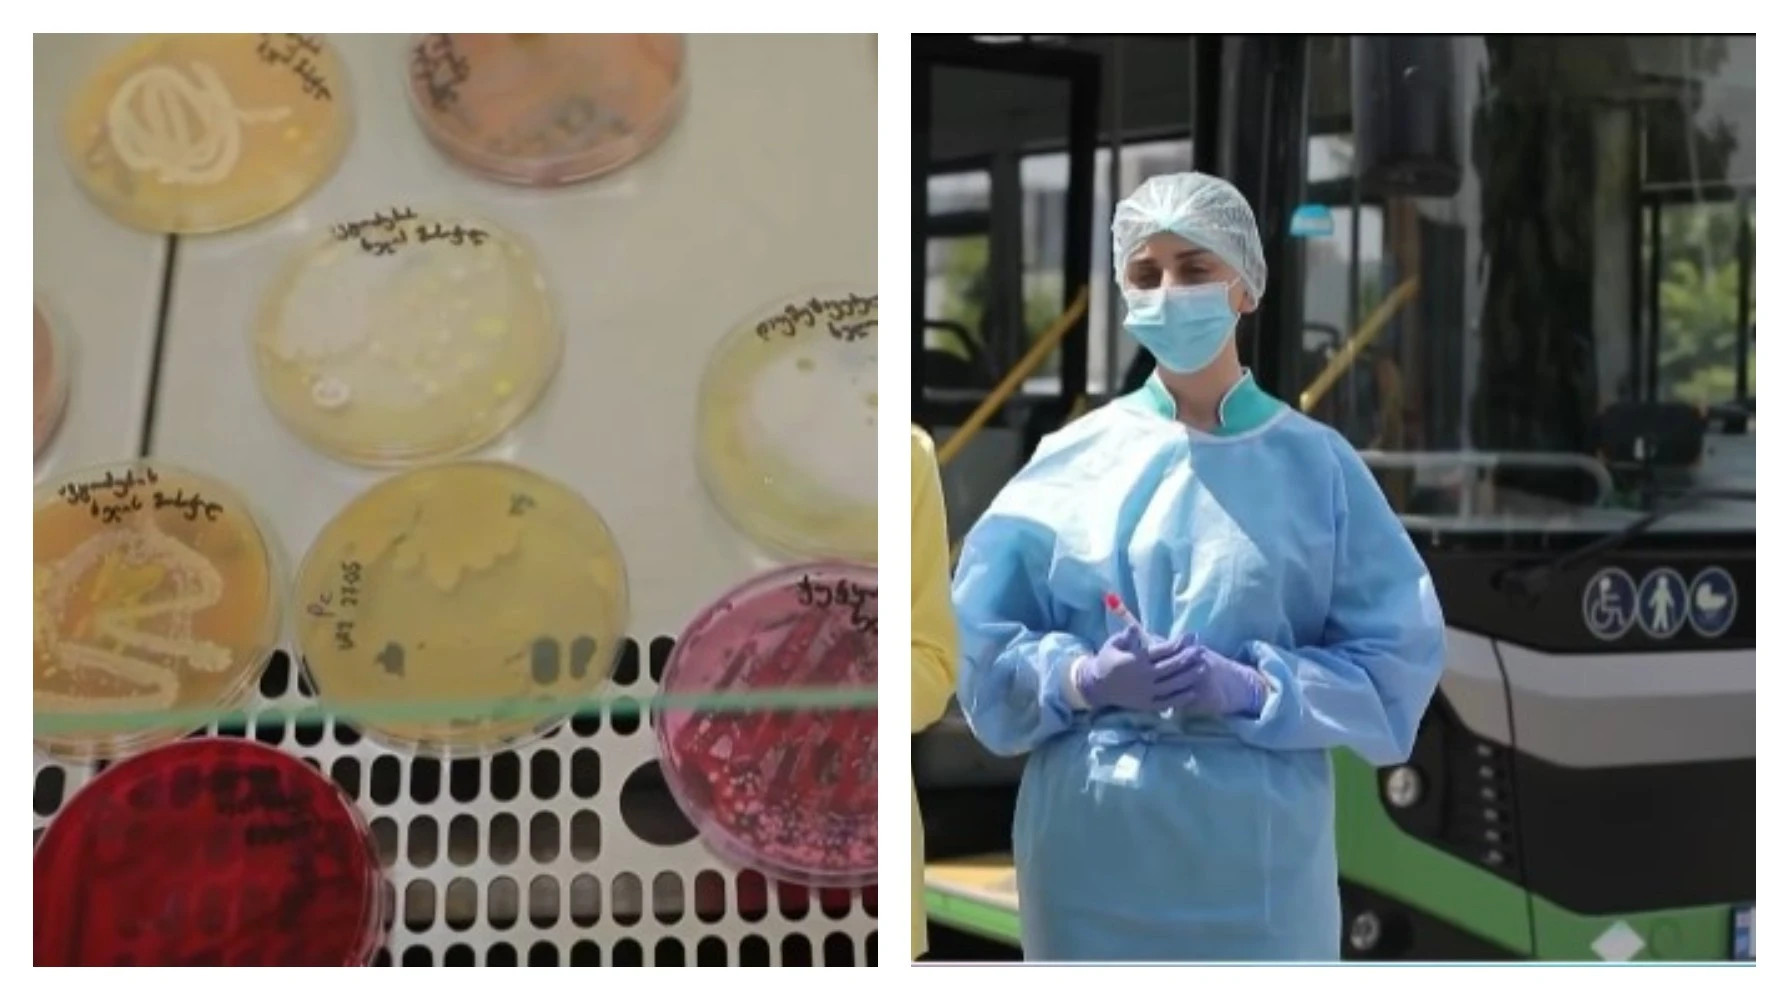

სმენის მსუბუქმა დაქვეითებამ აუცილებელი არ არის, რომ თქვენი ცხოვრების ხარისხზე მოახდინოს გავლენა. თუ ასაკთან ერთად შეამჩნიეთ, რომ სმენა გიუარესდებათ, ნუ იდარდებთ. მარტივ ყოველდღიურ ჩვევებს, სმუზის მიღებიდან დაწყებული, ფანჯრის გაღებით დამთავრებული მდგომარეობის სწრაფად გამოსწორება შეუძლია.
თუ ეძებთ გზებს სმენის ბუნებრივი გზით გასაუმჯობესებლად, გამოცემა Woman’s World-ის სამეცნიერო რჩევები შესანიშნავი გზამკვლევი იქნება თქვენთვის.
როგორ გავაუმჯობესოთ სმენა ბუნებრივი გზით
თქვენ უკვე იცით საფუძვლები, როგორიცაა ხმაურიან გარემოში ყურების დაცვა (მაგალითად, კონცერტებზე ან ბალახის თიბვისას). თუმცა, კიდევ ბევრი რამ შეგიძლიათ გააკეთოთ თქვენი სმენის ჯანმრთელობის დასაცავად.
ჩაიტარეთ გამოკვლევა
ყველაზე მნიშვნელოვანი, რაც ადამიანებმა სმენის დასაცავად უნდა გააკეთონ, არის სმენის შემოწმება. ბევრს ეს ტესტი სკოლის მერე არ გაუვლია. უმჯობესია რეგულარული შემოწმება 40 წლის ასაკიდან დაიწყოთ, რათა გქონდეთ საწყისი მონაცემები, რაც ექიმს ცვლილებების უკეთ კონტროლსა და მკურნალობაში დაეხმარება.
უარი თქვით ბამბის ჩხირებზე
ყურის გოგირდით დახშობა სმენის დაქვეითების ერთ-ერთი ყველაზე გავრცელებული მიზეზია და ამას ხშირად თავადვე ვიწვევთ ბამბის ჩხირების გამოყენებით. მიუხედავად იმისა, რომ ალტერნატიული საშუალებები (მაგალითად, სანთლით გამოწმენდა) შესაძლოა სასიამოვნო ჩანდეს, მათი ეფექტურობის მტკიცებულება არ არსებობს. პირიქით, არსებობს დამწვრობის მიღების რისკი. ექიმები გვირჩევენ ურეცეპტო წვეთებს, რომლებიც ჩვეულებრივ წყალბადის ზეჟანგისა და მინერალური ზეთის ნარევია - ეს უსაფრთხო და ეფექტურია.

გააღეთ ფანჯარა
როდესაც სახლში ტემპერატურის შესანარჩუნებლად ფანჯრებს კეტავთ, კონტაქტში შედიხართ საყოფაცხოვრებო ალერგენებთან. ეს იწვევს ორგანიზმში ჰისტამინის გამოყოფას, რომელიც ახშობს შუა ყურს - იქ, სადაც ხდება ბგერის დამუშავება. ანტიჰისტამინურ პრეპარატებზე ფულის ხარჯვისა და გვერდითი მოვლენების ნაცვლად, უბრალოდ გააღეთ ფანჯარა. ექსპერტები აღნიშნავენ, რომ განიავება, განსაკუთრებით დალაგების შემდეგ, საშუალებას აძლევს ალერგენებს გარეთ გავიდნენ. ასევე შეგიძლიათ გამოიყენოთ ჰაერის გამწმენდი.

გამოიყენეთ ყურსასმენები სმენის გასაუმჯობესებლად
სმენის დაქვეითებამ შეიძლება გაართულოს საუბრის აღქმა, განსაკუთრებით ტელეფონზე. მათთვის, ვისაც აქვს ნეიროსენსორული სმენის დაქვეითება (შიდა ყურის ან სმენის ნერვის დაზიანება), ეს პრობლემა მწვავედ დგას. თუმცა, კვლევები აჩვენებს, რომ სმარტფონის ჩვეულებრივი ყურსასმენები შეიძლება გამოიყენოთ როგორც სმენის აპარატები მსუბუქი ფორმების დროს. მკვლევრებმა დაადგინეს, რომ წყნარ გარემოში ისინი ისევე კარგად მუშაობენ, როგორც ძვირადღირებული აპარატები. მაგალითად, AirPods Pro-ს აქვს ჩაშენებული ფუნქცია Hearing Aid, რომელიც სწორედ ამისთვისაა შექმნილი.

მიირთვით ტკბილი კარტოფილი (ბატატი)
შემწვარი, პიურე თუ ნამცხვარში გამოყენებული - ტკბილი კარტოფილი სმენის გაუმჯობესებაში გეხმარებათ. ის მდიდარია A ვიტამინით, რომელიც იცავს შიდა ყურის უჯრედებს თავისუფალი რადიკალებისგან. კვლევის მიხედვით, მათ, ვისი რაციონიც მდიდარია A ვიტამინით, სმენის დაკარგვის რისკი 47%-ით ნაკლები აქვთ.
მოუსმინეთ მუსიკას
ჩვენ გვესმის არა ყურებით, არამედ ტვინით, ჩვენს ტვინს კი მუსიკა უყვარს. კვლევები აჩვენებს, რომ მუსიკალურ ინსტრუმენტზე დაკვრის სწავლა ნებისმიერ ასაკში აუმჯობესებს ფონური ხმაურის ფონზე ბგერების გარჩევის უნარს. უბრალოდ საყვარელი სიმღერის მოსმენაც კი ასტიმულირებს ტვინის იმ ნაწილებს, რომლებიც სმენაზეა პასუხისმგებელი.

მიირთვით თინუსი
კვლევამ აჩვენა, რომ ადამიანებს, რომლებიც კვირაში მინიმუმ ორჯერ მიირთმევენ თინუსს ან სხვა ცხიმიან თევზს, სმენის დაქვეითების რისკი 42%-ით უმცირდებათ. თუნდაც კვირაში ერთი პორცია თევზი უკვე დამცავ ეფექტს იძლევა. ომეგა-3 ცხიმოვანი მჟავები აძლიერებს სისხლის მიმოქცევას ლოკოკინაში (შიდა ყურის ნაწილი).

დალიეთ სმუზი
სმუზის ინგრედიენტები - რძე, იოგურტი, ბანანი და კენკრა - მდიდარია მაგნიუმით. ჟურნალში American Journal of Otolaryngology გამოქვეყნებული კვლევის თანახმად, მაგნიუმი აფართოებს სისხლძარღვებს და აძლიერებს ყურის მკვებავი სისხლის დინებას.

მიიღეთ ფოლიუმის მჟავა
ფოლიუმის მჟავა (ვიტამინი B9) მნიშვნელოვან როლს ასრულებს სმენის შენარჩუნებაში. კვლევამ აჩვენა, რომ 60 წელს გადაცილებულ ადამიანებს, რომლებსაც ფოლიუმის მჟავის მაღალი დონე აქვთ, 20%-ით ნაკლებად უვითარდებათ სმენის პრობლემები. ის ეხმარება ასაკობრივი სმენის დაქვეითების პრევენციას. მას შეიცავს არაქისი, ლობიო, კვერცხი, ბროკოლი, ფორთოხალი და ბურღულეული.
წყარო: rogor.ge


